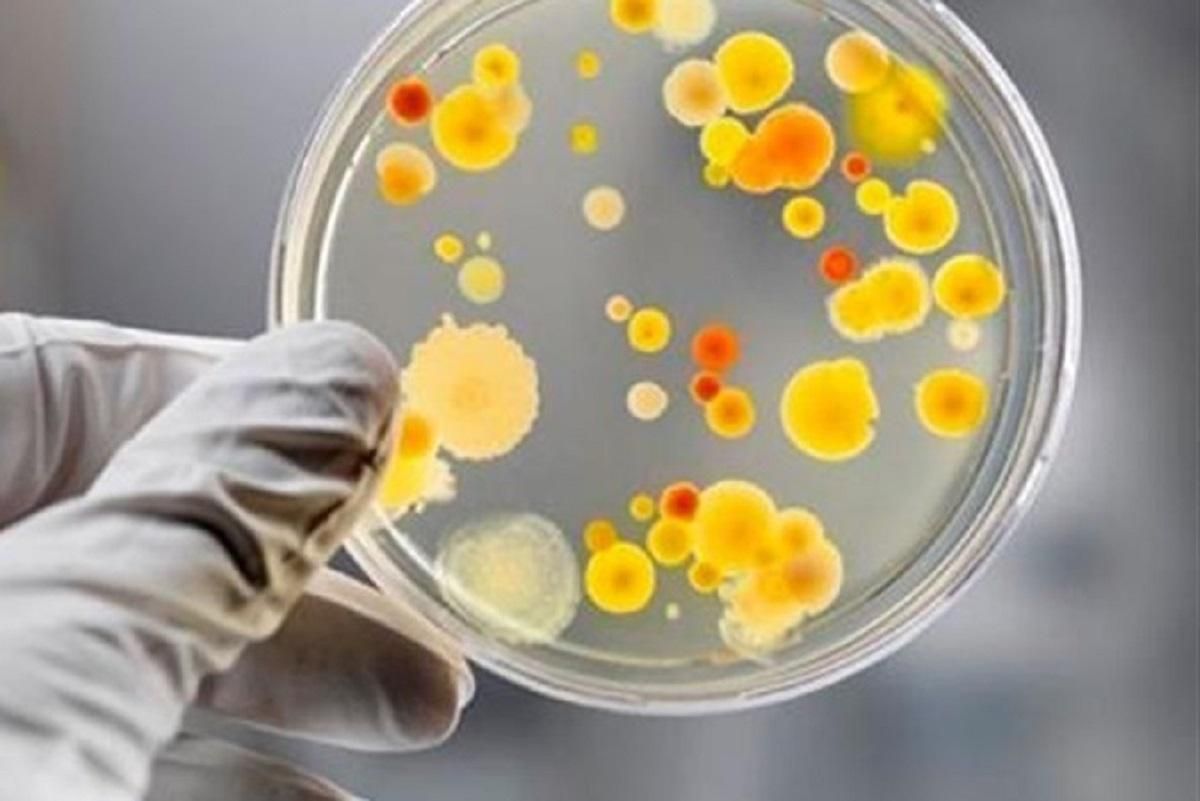
У Білій Церкві виявили сальмонельоз у закладі громадського харчування У Білій Церкві виявили сальмонельоз у закладі громадського харчування

Назва закладу не повідомляється. Його робота наразі призупинена.
Читайте також Знайшли ефективні ліки, які лікують рак кишечника на пізніх стадіях
Який заклад
Як повідомила одна з постраждалих, вона отруїлась у кафе "Дача" після п’ятничного обіду. Про це повідомляє сайт "Без Табу".
Які порушення норм виявили
Епідеміологи з’ясовують причину спалаху. Працівники Держпродспоживслужби вже виявили наступні порушення:
- не забезпечені належні санітарно-гігієнічні умови для зберігання харчових продуктів та виготовлення готових страв
- виявлена продукція з вичерпаним терміном реалізації
- до роботи допускають персонал без проходження медичного огляду та бактеріологічного обстеження
Відібрали зразки
Проведено відбір зразків з обладнання, готових страв, продовольчої сировини й питної води), Персонал закладу обстежено на виявлення носіїв збудників кишкових інфекцій.
Відсторонено від роботи 5 осіб. Вилучено з обігу та передано на утилізацію непридатну до споживання продукцію.